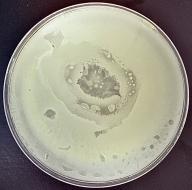
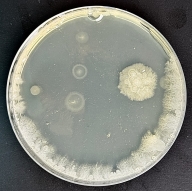
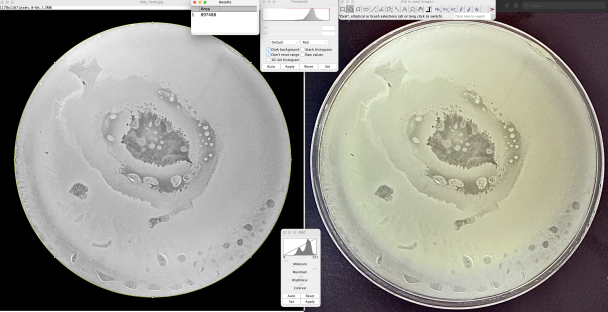
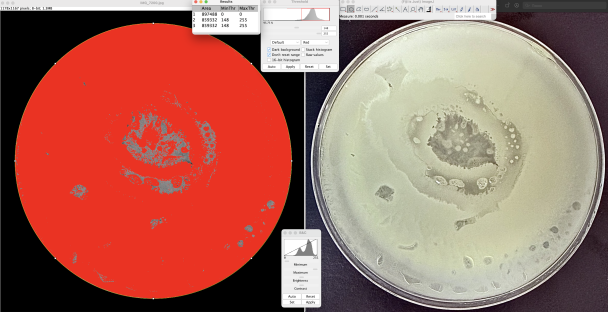

В школьной среде учащиеся ежедневно контактируют с большим количеством предметов и поверхностей: партами, столами, дверными ручками, учебными принадлежностями. После этого руки соприкасаются с тетрадями, учебниками, лицом и одеждой, что создаёт условия для переноса микроорганизмов. При этом загрязнение рук не всегда заметно визуально, однако бактериальная нагрузка может быть высокой.
Согласно данным санитарно-гигиенических исследований, именно руки являются одним из основных путей передачи микроорганизмов в образовательных учреждениях [1, с. 31–34]. В связи с этим гигиена рук рассматривается как один из наиболее эффективных и доступных способов профилактики инфекционных заболеваний среди учащихся.
Наиболее распространёнными методами гигиенической обработки рук являются мытьё с мылом и использование антисептических средств. Мытьё рук обеспечивает механическое удаление загрязнений и части микроорганизмов с поверхности кожи. Антисептические средства, в свою очередь, оказывают химическое воздействие на бактерии и позволяют значительно снизить их количество за короткое время [2].
Однако эффективность гигиенической обработки рук может изменяться в зависимости от условий окружающей среды. В регионах с высокой температурой и повышенной влажностью создаются благоприятные условия для выживания и восстановления микроорганизмов. В таких условиях бактерии могут быстрее восстанавливать численность после обработки рук, что снижает продолжительность защитного эффекта [3].
Актуальность настоящего исследования заключается в необходимости экспериментально оценить эффективность различных способов гигиенической обработки рук учащихся в условиях, приближённых к реальным, а также провести сравнение результатов, полученных в разных климатических зонах.
Теоретические основы гигиены рук в школьной среде
Гигиена рук является важным элементом системы профилактики инфекционных заболеваний. На поверхности кожи рук постоянно присутствуют микроорганизмы, часть которых относится к нормальной микрофлоре, а часть может представлять потенциальную опасность для здоровья человека. При контакте рук с загрязнёнными поверхностями количество микроорганизмов значительно увеличивается.
Микроорганизмы способны сохраняться на коже рук в течение длительного времени, особенно при наличии влаги. При этом влажная среда способствует не только выживанию бактерий, но и их активному размножению. В условиях высокой влажности микроорганизмы могут быстрее восстанавливать численность после гигиенической обработки рук.
Мытьё рук с мылом способствует механическому удалению загрязнений и микроорганизмов. При этом эффективность мытья рук зависит от продолжительности процедуры, температуры воды и тщательности обработки поверхности кожи. Спиртовые антисептики оказывают химическое воздействие на микроорганизмы, разрушая их клеточные структуры, что приводит к быстрой гибели бактерий [4].
Несмотря на высокую эффективность антисептических средств, их действие может быть кратковременным, особенно в условиях повышенной влажности и повторного контакта с загрязнёнными поверхностями. Это делает актуальным исследование эффективности различных гигиенических средств в реальных условиях школьной среды.
Цель и задачи исследования
Цель исследования — изучить эффективность гигиенической обработки рук учащихся различными средствами в условиях различной температуры и влажности воздуха.
Для достижения поставленной цели были определены следующие задачи :
- определить уровень бактериального загрязнения рук учащихся до гигиенической обработки;
- оценить изменение бактериального загрязнения рук после обработки спиртовыми антисептиками и мытья рук с мылом;
- сравнить эффективность гигиенических средств в условиях умеренного и влажного климата;
- проанализировать влияние климатических условий на результат гигиенической обработки рук.
Материалы и методы исследования
Исследование проводилось в двух странах: Республике Беларусь и Демократической Социалистической Республике Шри-Ланка. В Республике Беларусь эксперимент выполнялся в закрытом помещении образовательного учреждения при температуре воздуха 22–24 °C и умеренной влажности. В Шри-Ланке исследование проводилось при температуре воздуха 30–34 °C и высокой влажности, достигающей 98 %.
Объектом исследования являлись руки учащихся.
Предметом исследования — бактериальное загрязнение рук до и после гигиенической обработки.
Для отбора проб использовались стерильные ватные тампоны, которыми выполнялись смывы с поверхности рук. Для гигиенической обработки применялись следующие средства:
- антисептик белорусского производства с содержанием спирта 70 %;
- антисептик шри-ланкийского производства с содержанием спирта 70 %;
- мытьё рук с мылом и водой.
Организация эксперимента
Эксперимент проводился по единой схеме. Сначала выполнялся смыв с немытых рук учащегося. Затем проводилась гигиеническая обработка рук выбранным средством. После этого выполнялся повторный смыв для оценки эффективности обработки.
Для каждого этапа использовались отдельные стерильные тампоны, что исключало возможность перекрёстного загрязнения. Полученные смывы наносились на чашки Петри с питательной средой. Инкубация образцов проводилась в течение 48 часов при температуре 35–36 °C.
После завершения инкубации выполнялась фотосъёмка чашек Петри для дальнейшего анализа.
|
|
|
|
|
а |
б |
в |
Рис. 1. Чашки Петри с бактериальным ростом после инкубации образцов, полученных со смывов с рук учащихся:
а — до гигиенической обработки;
б — после обработки спиртовым антисептиком;
в — после мытья рук с мылом.
Метод количественного анализа бактериального роста
Для количественной оценки бактериального загрязнения использовался метод определения относительной площади поверхности чашки Петри, занятой микроорганизмами. Анализ изображений проводился с помощью программы ImageJ.
Сначала загружалось исходное изображение чашки Петри. Затем выполнялось выделение области бактериального роста и расчёт площади, занятой микроорганизмами. Полученные значения выражались в процентах от общей площади чашки Петри.
|
|
|
а |
|
|
|
б |
Рис. 2. Этапы цифровой обработки изображений чашек Петри в программе ImageJ: а — определение относительной площади чашки Петри; б — определение относительной площади, занятой микроорганизмами
Результаты исследования
До гигиенической обработки руки учащихся характеризовались высоким уровнем бактериального загрязнения. В большинстве случаев площадь бактериального роста превышала 90 % площади чашки Петри, что свидетельствует о значительной бактериальной нагрузке. Данные представлены в таблице 1.
Таблица 1
Бактериальное загрязнение рук учащихся до и после гигиенической обработки (Республика Беларусь)
|
Гигиеническое средство |
Доля бактериального роста, % |
|
До обработки |
92,50 |
|
Антисептик (Беларусь, 70 %) |
1,37 |
|
Антисептик (Шри-Ланка, 70 %) |
5,03 |
|
Мытьё рук с мылом |
19,09 |
В условиях Шри-Ланки эффективность всех исследуемых средств была несколько ниже. Данные представлены в таблице 2.
Таблица 2
Бактериальное загрязнение рук учащихся до и после гигиенической обработки (Шри-Ланка)
|
Гигиеническое средство |
Доля бактериального роста, % |
|
До обработки |
95,75 |
|
Антисептик (Беларусь, 70 %) |
2,16 |
|
Антисептик (Шри-Ланка, 70 %) |
6,20 |
|
Мытьё рук с мылом |
20,90 |
Результаты
Полученные результаты показывают, что гигиеническая обработка рук является эффективным способом снижения бактериального загрязнения. Однако установлено, что эффективность обработки зависит не только от используемого средства, но и от условий окружающей среды.
В условиях высокой влажности наблюдается более быстрое восстановление бактериального роста, что приводит к увеличению остаточного загрязнения после обработки. Мытьё рук с мылом демонстрирует стабильный, но менее выраженный эффект по сравнению со спиртовыми антисептиками.
Практическое значение работы заключается в возможности использования полученных результатов при организации гигиенических мероприятий в школьной среде. Результаты исследования показывают, что в условиях повышенной влажности требуется более частая гигиеническая обработка рук и использование антисептических средств.
По результатам работы были сделаны следующие выводы:
- Руки учащихся до гигиенической обработки имеют высокий уровень бактериального загрязнения.
- Спиртовые антисептики обеспечивают более эффективное снижение бактериальной нагрузки по сравнению с мытьём рук с мылом.
- В условиях высокой влажности эффективность гигиенической обработки рук снижается.
- Климатические условия необходимо учитывать при организации гигиенических мероприятий в школе.
Литература:
- Лисов Н. Д. Биология: учебное пособие для 7 класса. — Минск: Народная асвета, 2022.
- Санитарные нормы и правила для учреждений общего среднего образования.
- World Health Organization. Water, sanitation and hygiene in schools.
- Akinsulie O. C. Hand hygiene and infection prevention. — 2024.